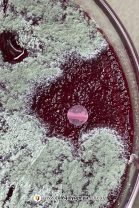

Los alumnos de 6to 1ra, en el espacio curricular Salud, fueron al laboratorio a observar los cultivos que habían realizado la semana anterior. Se encontraron con varias sorpresas! procedieron a la observación y tipificación macroscópica de las colonias. Luego hicieron preparados para observar al microscopio, a partir del cual pudieron ver diferentes organismos y clasificarlos según su forma.
Asimismo, comprobaron la acción inhibitoria del crecimiento del hipoclorito de sodio (lavandina). Los alumnos comentaron que fue una experiencia muy gratificante.
Noticia anterior/siguiente:
“El pequeño vampiro” llegó a 5to grado
Photoshoot de las representaciones de “Victoria’s Secrets Scandals”

Seguí al colegio